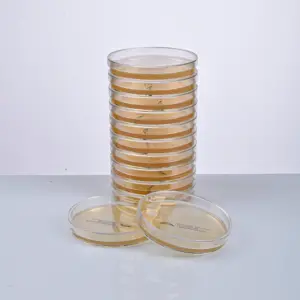
FERTIGER CHROMOGENER KPC-AGAR
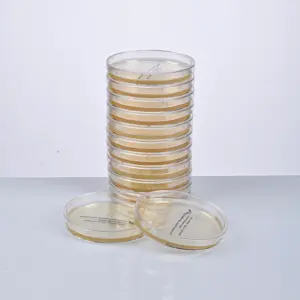
FERTIGER CHROMOGENER MRSA-AGAR
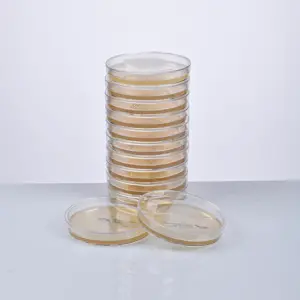
FERTIGER CHROMOGENER UTI-AGAR
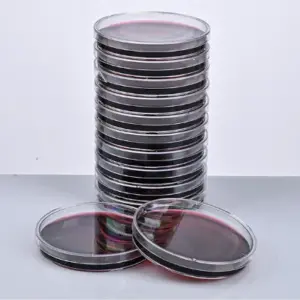
FERTIGER EMB-AGAR

Ergebnisse 13 – 24 von 78 werden angezeigt

Aklab Group ist ein führender Anbieter von hochwertigen Gesundheitsprodukten und -dienstleistungen. Mit unserem Engagement für Innovation und Exzellenz bieten wir weltweit zuverlässige, nachhaltige und ethische Lösungen im Gesundheitswesen. Vertrauen Sie auf unsere zertifizierte Qualität und unser erfahrenes Team, um Ihre Gesundheit zu unterstützen.